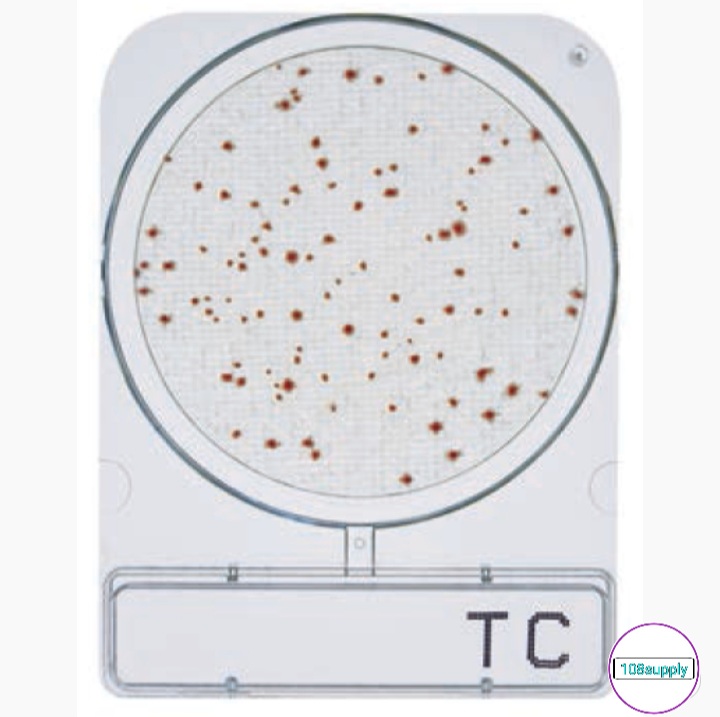
ชุดทดสอบแบคทีเรียในอากาศ “Compact Dry TC” จำนวน 20 การทดสอบ/กล่อง
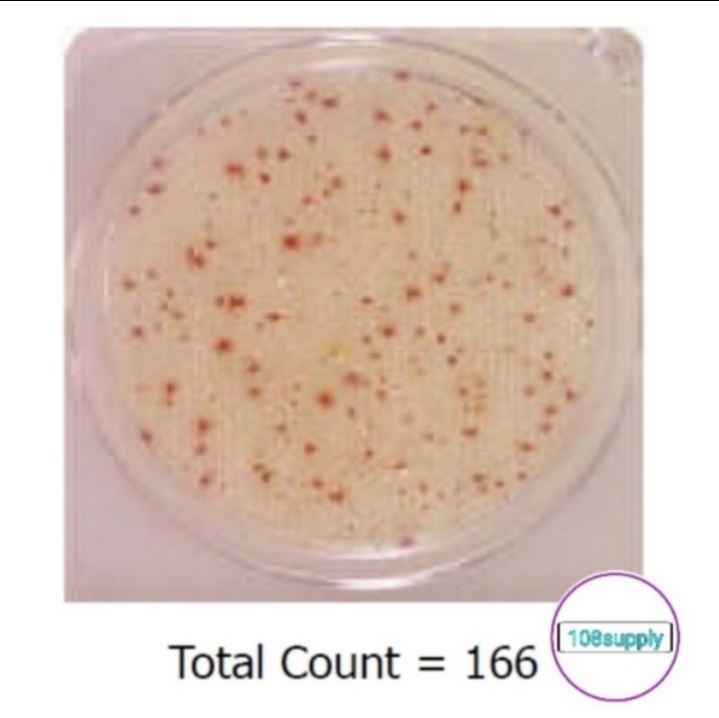
ชุดทดสอบแบคทีเรียในอากาศ “Compact Dry TC” จำนวน 20 การทดสอบ/กล่อง

ชุดตรวจแบคทีเรียในอากาศ
Test Kit Microbial “Compact Dry TC”
Compact Dry TC เป็นจานเลี้ยงเชื้อสำเร็จรูป สำหรับการตรวจหาจำนวนแบคทีเรียทั้งหมด ประกอบด้วยอาหารเลี้ยงเชื้อNutrient Standard Agar และ Tetrazolium ซึ่งเป็น Salt Redox Indicator โดยจะให้โคโลนีสีแดง
วิธีทดสอบ
- ใช้หลอดฉีดยาดูดน้ำยาทดสอบTC จำนวน 1 ml
- เปิดฝา Compact DryTC และหยดน้ำยาทดสอบTC จำนวน 1มล. ลงบนกลางแผ่น
- ทิ้งให้น้ำยาทดสอบ TC กระจายตัวไปทั่วแผ่นโดยอัตโนมัติประมาณ 1 นาที
- นำCompact Dry TC ไปวางในห้องที่ต้องการตรวจโดยเปิดฝาเพลททิ้งไว้15นาที( 3เพลทต่อ1 จุดการทดสอบ)
- ปิดฝาCompact Dry TC และเขียนข้อมูลตัวอย่างลงบนแผ่นสติ๊กเกอร์ แล้วนำไปติดบน Plate
- นำ Compact Dry TC คว่ำแล้วใส่ซองซิปนำเข้าตู้บ่ม(ที่อุณหภูมิ 33-37C หรือที่อุณหภูมิห้อง) เป็นเวลา 24-28 ชั่วโมง
|
การแปลผล
เมื่อบ่มเชื้อครบ 24-48 ชั่วโมงแล้ว ตรวจสอบผลพลิกดูหลังเพทล ถ้ามีการปนเปื้อนเชื้อจุลินทรีย์จะมีจุดสีปรากฏให้เห็น
|
การแปลผล
เมื่อบ่มเชื้อครบ 24-48 ชั่วโมงแล้ว ตรวจสอบผลพลิกดูหลังเพทล ถ้ามีการปนเปื้อนเชื้อจุลินทรีย์จะมีจุดสีปรากฏให้เห็น

ตรวจนับจุดสีแดง
|
|
วิธีการทำลาย “Compact Dry TC”
- ใช้แอลกอฮอล์หรือน้ำยาฆ่าเชื้อราดให้ท่วมแล้วเก็บใส่ซองซิปทิ้งไว้ ประมาณ 10 นาที
การเก็บรักษา
- ซองที่ยังไม่ได้เปิด : เก็บไว้ที่อุณหภูมิห้อง (29-31C) ไม่ควรเก็บในตู้เย็น
- ซองที่เปิดแล้ว : พับปากซองและปิดด้วยเทปกาว เก็บไว้ที่อุณหภูมิห้อง (29-31C)ไม่ควรเก็บในตู้เย็นและใช้ภายใน30 วัน
|
|